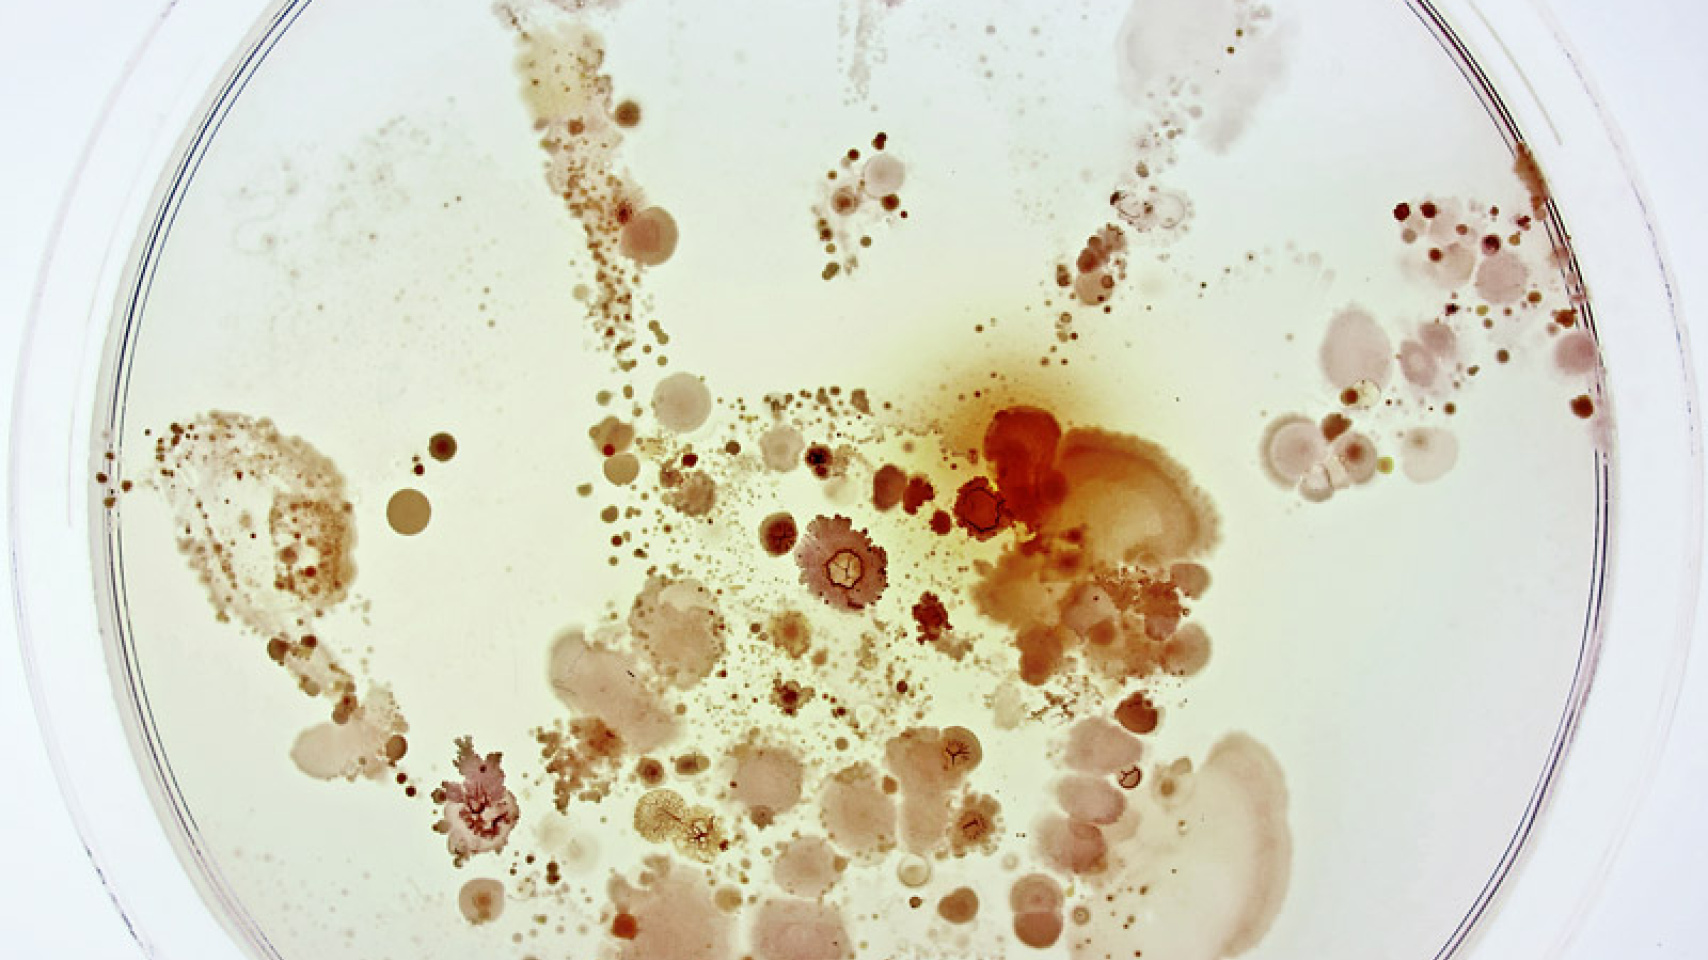
"¿Qué esconde la mano de un niño?", fotografía premiada en el certamen convocado por CSIC y FECYT

Dos investigadores de la Universidad de Salamanca se alzan con el Primer Premio del certamen FOTCIENCIA
‘¿Qué esconde la mano de un niño?’, de Raúl Rivas González y Lorena Celador Lera, muestra el crecimiento de microorganismos a partir de la huella dejada por una niña
El profesor Raúl Rivas González y la investigadora Lorena Celador Lera, del Departamento de Microbiología y Genética de la Universidad de Salamanca, han obtenido el Primer Premio en la categoría general del Certamen de Fotografía Científica FOTCIENCIA, convocado por el Consejo Superior de Investigaciones Científicas (CSIC) y la Fundación Española para la Ciencia y la Tecnología (FECYT).
La fotografía por la que han logrado el premio de la 13ª edición del certamen se titula “¿Qué esconde la mano de un niño?” y muestra el crecimiento de diversos microorganismos a partir de la huella dejada por una niña de 6 años en una placa de cultivo. La imagen, tomada tras incubar la placa durante dos días, refleja colonias de levaduras y una gran diversidad de colonias de bacterias en distintas formas y tonalidades. El objetivo era demostrar a alumnos de Infantil y Primaria de un colegio de Salamanca la importancia que tiene lavarse las manos y, al mismo tiempo, enseñarles que la presencia de microorganismos en nuestra piel es algo habitual.
FOTCIENCIA es el certamen de fotografía más prestigioso de España. Convocado por CSIC y FECYT, su objetivo es acercar la ciencia y la tecnología a los ciudadanos mediante una visión artística y estética surgida a través de imágenes científicas y un comentario escrito del hecho científico que ilustran. El jurado estaba compuesto por profesionales relacionados con la fotografía, la microscopía y la divulgación científica.
Como en ediciones anteriores, las fotografías premiadas, junto a otras seleccionadas entre las casi 700 que se han presentado, serán incluidas en un catálogo y formarán parte de una exposición itinerante que recorrerá diferentes museos y centros de España durante 2016.
________________________________________
Más información:
Raúl Rivas González, profesor de Microbiología de la Universidad de Salamanca
Telf.: 923 294500, ext. 1919. Correo electrónico: raulrg@usal.es
Fotografía premiada: http://www.fotciencia.es/Publico/Galeria/ResumenEdicion.aspx?Anno=2015
________________________________________